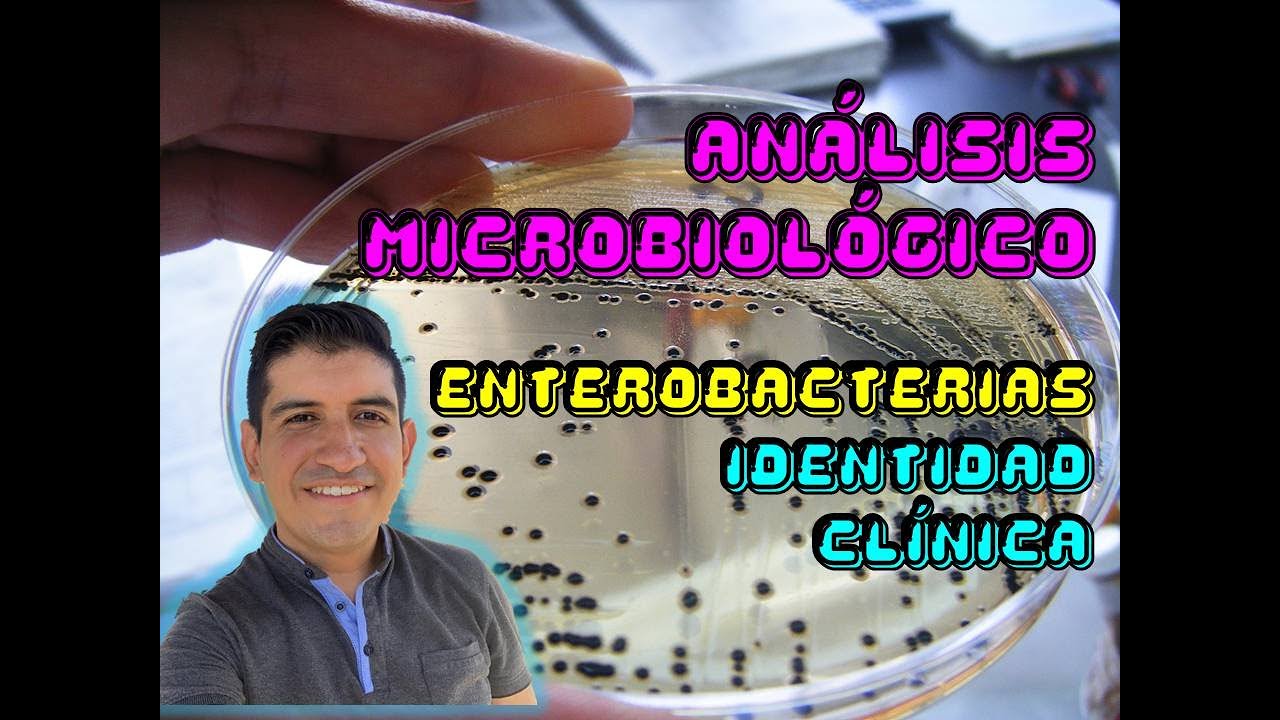
Enterobacterias

Видео с ютуба Enterobacterias

Enterobacterias

ESCHERICHIA COLI -MICROBIOLOGIA (BACTÉRIAS PATOGÊNICAS) - ENTEROBACTÉRIAS

Enterobactérias 1: Shigella, Salmonella, Yersinia - Resumo - Microbiologia
Enterobacterias

ЭНТЕРОБАКТЕРИЯ ЧАСТЬ 1

Bacteriologia Clínica -Aula 05: Enterobactérias I

Enterobactérias 2 - Aspectos Gerais

ENTEROBACTÉRIAS

SHIGELLA - MICROBIOLOGIA (BACTÉRIAS PATOGÊNICAS) - ENTEROBACTÉRIAS

Família Enterobacteriaceae MED 2021

Enterobactérias (parte 01)

Enterobacterias

ENTEROBACTÉRIAS EAD vídeo 20 1

Enterobacterias

Identificação de Enterobactérias com Série Bioquímica

Enterobacterias I

Aula enterobactérias I

Microbiologia. Enterobacterias

BACTERIOLOGÍA 🦠🦠🔬 - ENTEROBACTERIAS - Escherichia coli

Энтеробактерии